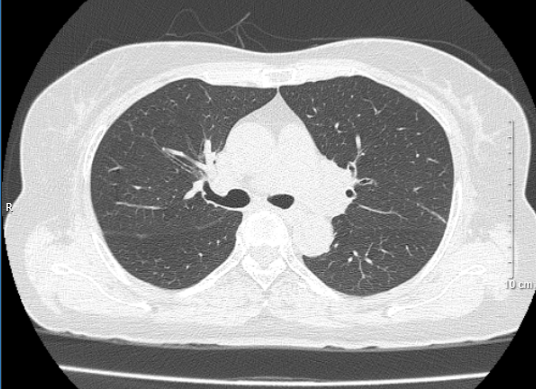

Ngày đăng: 16/10/2023
Ngày đăng: 16/10/2023Ung thư phổi là một trong những loại loại ung thư phổ biến, có tỷ lệ mắc và tỉ lệ tử vong rất cao ở nam giới, nhưng thường được chẩn đoán ở giai đoạn muộn. Theo GLOBOCAN 2020, số ca được chẩn đoán ung thư phổi mới là hơn 2,2 triệu ca đứng hàng thứ 2 về tỉ lệ mắc mới.
Ung thư phổi được chia thành ung thư phổi không tế bào nhỏ và ung thư phổi tế bào nhỏ (Small cell lung cancer: SCLC). SCLC chiếm khoảng 15% ung thư phổi, khoảng 70% bệnh nhân lúc chẩn đoán đã ở giai đoạn lan tràn. SCLC tiên lượng thường rất xấu, nếu không điều trị thời gian sống trung bình từ khi chẩn đoán chỉ từ 2 đến 4 tháng. Hóa trị và xạ trị là hai phương pháp chủ yếu trong điều trị SCLC. Mặc dù SCLC đáp ứng tốt với hóa trị (tỷ lệ đáp ứng là 70-80% với khoảng 50% bệnh nhân đáp ứng hoàn toàn với hóa trị ở giai đoạn khu trú) nhưng tỉ lệ sống sau 5 năm chỉ từ 5% đến 10% do bệnh tái phát.
Sau đây chúng tôi xin trình bày một trường hợp lâm sàng bệnh nhân mắc ung thư phổi tế bào nhỏ đáp ứng hoàn toàn sau điều trị.
Họ và tên: N.T.L; Giới: Nữ; Tuổi: 66
Lý do vào viện: Đau ngực trái, ho khan
Tiền sử: Đái tháo đường typ 2 đang điều trị thuốc theo chuyên khoa nội tiết.
Bệnh sử: Bệnh nhân ở nhà xuất hiện đau ngực trái tăng dần khoảng 15 ngày kèm theo ho khan, không sốt, không khó thở, chưa điều trị gì tại nhà. Bệnh nhân đi khám chụp X-quang tình cờ phát hiện khối u ở phổi trái nên được chuyển đến Bệnh viện Bạch Mai để khám, chẩn đoán và điều trị.
Tình trạng lúc vào viện:
Bệnh nhân tỉnh, G 15 điểm
Toàn trạng: ECOG 2 (*)
Chiều cao: 155cm; cân nặng: 54kg
Đau ngực trái: VAS 5-6 điểm (*)
Không có triệu chứng của các cơ quan khác
(* Chú thích: chỉ số ECOG đánh giá triệu chứng lâm sàng và khả năng hoạt động của bệnh nhân, mức 0 điểm tương ứng với không có triệu chứng và hoạt động bình thường, mức 4 điểm tương ứng với có nhiều triệu chứng và nằm toàn bộ thời gian; thang điểm VAS là thang điểm giá trị đo lường cường độ đau có giá trị từ 0-10, ở mức 0 là không đau và mức 10 là đau dữ dội không thể chịu nổi).
Xét nghiệm cận lâm sàng:
 |
 |
Hình 1: Hình ảnh cắt lớp vi tính lồng ngực lúc mới chẩn đoán (mũi tên xanh: khối ở trung thất giữa; mũi tên đỏ: nốt đặc ở phổi cùng bên).
Chẩn đoán xác định: Ung thư phổi tế bào nhỏ, giai đoạn khu trú, T4N0M0/Đái tháo đường typ 2.
Điều trị: Bệnh nhân có thể trạng kém, nên không thể tiến hành hóa xạ trị đồng thời. Vì vậy bệnh nhân đã được chỉ định điều trị hóa chất trước để giảm bớt triệu chứng cho bệnh nhân sau đấy sẽ cân nhắc xạ trị.
Đánh giá đáp ứng sau điều trị:
| Chỉ số | Trước điều trị | Sau điều trị 1 chu kì | Sau điều trị 3 chu kì |
| ProGRP (ng/l) | 773,9 | 152,4 | 77,8 |
 |
|
Hình 2: Hình ảnh trước điều trị (bên trái): Hình ảnh khối u và tổn thương di căn phổi cùng bên (mũi tên đỏ). Hình ảnh sau điều trị (bên phải): không còn khối u sau 3 chu kì điều trị
 |
 |
Hình 3: Hình bên trái (trước điều trị): Hình ảnh khối u (mũi tên vàng). Hình bên phải (sau điều trị): không còn tổn thương di căn phổi cùng bên sau 3 chu kì điều trị
Trong quá trình điều trị bệnh nhân xuất hiện một số tác dụng phụ: nôn, mệt mỏi, chán ăn, chưa phát hiện các tác dụng phụ khác.
Hiện tại bệnh nhân đã điều trị 3 chu kì hóa chất và tiếp tục được điều trị tiếp theo phác đồ hiện tại kết hợp với xạ trị tại chỗ.
GS. TS Mai Trọng Khoa; PGS. TS Phạm Cẩm Phương;
BSCK.II Lê Viết Nam; BSNT Cao Văn Trung - Trung tâm YHHN&UB, BV Bạch Mai